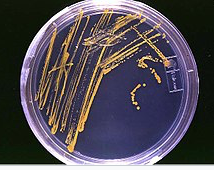

Les eliminacions del malalt i la presa de mostres biològiques
L’observació i l’anàlisi de mostres obtingudes del pacient tenen un paper fonamental en la seva observació i el control del seu estat de salut. Aquestes mostres biològiques permeten fer diagnòstics, establir tractaments i controlar l’evolució de les malalties.
Una mostra biològica és una petita fracció de material biològic obtinguda de l’organisme per analitzar-la.
Les mostres biològiques són de diferents productes i substàncies. Poden ser de material excretat per l’organisme o bé extret de l’organisme per algun procediment. L’organisme elimina o excreta substàncies a través de l’orina, la femta o la suor. Els òrgans, glàndules o conductes que tenen entre les seves funcions l’eliminació de residus metabòlics de l’organisme s’anomenen emuntoris.
Les substàncies eliminades pels emuntoris no són totes toxines o residus perjudicials. De vegades la toxicitat no només depèn del tipus de substància, sinó de la quantitat. Així, en el nostre organisme hi ha metabòlits o substàncies que no són tòxiques o perjudicials, però que acumulades per sobre de determinats nivells sí que produeixen efectes nocius. Per tant, els emuntoris eliminaran les substàncies nocives i l’excés de metabòlits que per algun motiu s’han acumulat.
Emuntori
Prové del verb llatí emungo, que vol dir ‘netejar’ o ‘expulsar’. Es diu de qualsevol òrgan o part del cos que serveix per evacuar o excretar.
Hi ha diverses mostres que es fan servir més habitualment per obtenir informació sobre l’estat de salut. D’una banda, les eliminacions com l’orina, la femta o l’esput. De fet, en els registres d’infermeria que formen part de la història clínica s’inclouen dades sobre les eliminacions del malalt. I d’altra banda, a més de les eliminacions, s’usen altres mostres biològiques que s’extreuen de l’organisme i proporcionen molta informació com la sang, els exsudats o el líquid cefalorraquidi.
El personal d’infermeria normalment s’ocupa d’obtenir i recollir aquestes mostres. Formen part de les tasques de l’auxiliar d’infermeria la recollida de les eliminacions i la preparació del material necessari per a l’obtenció de mostres, així com el coneixement de les tècniques usades en cada cas.
Obtenció de mostres biològiques
Les manifestacions clíniques que presenta un pacient i l’exploració per part del facultatiu orienten el diagnòstic, que sovint es confirma amb proves diagnòstiques. Moltes d’aquestes proves es fan a partir de l’obtenció de mostres biològiques. Amb les mostres obtingudes es fan anàlisis bioquímiques, microbiològiques, immunològiques, genètiques, hormonals o hematològiques.
És molt important seguir tècniques adequades per a la recollida de mostres, per evitar errors i possibles infeccions nosocomials. També cal que les característiques dels envasos que s’han d’utilitzar per recollir-les i el transport de les mostres garanteixi la fiabilitat dels resultats. Quan es recull una mostra se n’han d’observar les característiques. Les mostres presenten variacions, algunes de les quals són dins de la normalitat i d’altres corresponen a signes d’anormalitat i malaltia.
Moltes mostres biològiques les obté el personal d’infermeria amb la col·laboració del TCAI; però d’altres les pot recollir el TCAI amb la col·laboració del pacient, o sense aquesta col·laboració.
En qualsevol cas, és important sempre tenir en compte alguns aspectes:
- Preparar prèviament tot el material necessari per obtenir la mostra, recollir-la, conservar-la i transportar-la.
- Verificar les dades del full de sol·licitud, que han de correspondre a la persona indicada i ser correctes.
- Enganxar en el recipient de recollida una etiqueta amb totes les dades que permetin la identificació del pacient i de la mostra.
- Explicar el procediment al pacient i, si és el cas, demanar-li que col·labori.
- En el cas de mostres per sospita d’infecció, fer la presa de la mostra al lloc de la infecció.
- Evitar la contaminació amb la flora bacteriana normal de la zona on es recull la mostra i obtenir la mostra de forma asèptica.
- Deixar transcórrer com menys temps millor entre la presa de la mostra i la seva arribada al laboratori.
- Recollir la quantitat suficient de material necessari perquè totes les proves sol·licitades es puguin dur a terme adequadament.
- Identificar correctament la mostra amb el nom del pacient, el número d’història i la localització.
- Comprovar que les dades de la mostra es corresponen amb les de la petició.
Cada tipus de mostra requereix un material i unes condicions diferents per a la seva recollida.
Mostres de sang
La sang, a través del sistema circulatori, arriba a totes les parts de l’organisme, els aporta els nutrients necessaris i en retira els residus. Si algun òrgan o sistema de l’organisme no funciona bé, pot produir modificacions en la composició de la sang. Per tant, la sang ofereix molta informació sobre la salut de les persones. L’anàlisi o examen de sang mesura el nombre i tipus de cèl·lules a la sang i tots els altres elements que conté alliberats al torrent sanguini per altres òrgans. Per això, les anàlisis de sang poden ajudar a diagnosticar malalties d’altres òrgans o aparells i ajuden els metges a verificar l’estat general de salut dels pacients.
Algunes de les alteracions que es poden produir a la sang són:
- Canvis en el nombre o en la forma de les seves cèl·lules: les hematies, els leucòcits, les plaquetes, els factors de coagulació, anèmia, leucèmia, leucocitosi, trombocitopènia, etc.
- Canvis en la concentració de substàncies com la glucosa, el colesterol, els triglicèrids, la urea, la creatinina, d’enzims com les transaminases, la fosfatasa alcalina, d’hormones, etc.
- Canvis en elements que confereixen immunitat, els anticossos o la presència d’antígens.
- Canvis en la concentració dels gasos sanguinis.
La mostra de sang es pot obtenir dels capil·lars, de les venes i de les artèries.
Les mostres de sang capil·lar, arterial o venosa tenen finalitats diferents i el procediment per recollir la mostra també és diferent, ja que les artèries es troben més profundes que les venes, que solen ser més visibles a través de la pell i més fàcilment localitzables per palpació.
Les funcions de l’auxiliar d’infermeria en relació amb l’obtenció de mostres de sang són: col·laborar amb el personal d’infermeria i preparar/recollir el material necessari per a la realització del procediment.
Recollida de sang per punció capil·lar
L’obtenció de sang capil·lar és un mètode molt senzill, ràpid i segur. Aquesta tècnica permet recollir una mostra de sang petita per a determinacions bioquímiques sobre tires reactives, com la determinació del colesterol en sang o la determinació de la glucosa en el control de la diabetis (vegeu figura).
| PROTOCOL DE RECOLLIDA DE MOSTRA DE SANG CAPIL·LAR |
|---|
| OBJECTIU |
| • Conèixer els valors de components bioquímics de la sang d’una persona. |
| MATERIAL NECESSARI |
| • Dispositiu per punxar el dit i llancetes • Aparell mesurador (glucòmetre) o pipeta de vidre o portaobjectes • Gasa • Guants d’un sol ús |
| PROCEDIMENT |
| 1. Preparar el material. |
| 2. Rentar-se les mans i col·locar-se els guants. |
| 3. Comprovar la identitat del pacient. |
| 4. Informar de la tècnica el pacient i demanar-li col·laboració. |
| 5. Preservar la intimitat del pacient i col·locar-lo en la posició adequada. Si és possible, assegut. |
| 6. Triar la zona de la punció. Normalment són els dits de les mans i preferentment les parts laterals, ja que el mig de la polpa és una zona més sensible al dolor. També es pot fer la punció al lòbul de l’orella, als dits dels peus, etc. |
| 7. Per afavorir una millor sortida de la gota de sang, fer un massatge lleuger al dit, posant la mà cap per avall i per sota del nivell del cor. |
| 8. Desinfectar la zona de punció (dit) amb una gasa mullada amb alcohol o povidona iodada. |
| 9. Punxar el dit amb la llanceta, una sola vegada, i deixar perdre la primera gota. |
| 10. Recollir les següents gotes sobre la tira reactiva, el tub capil·lar o un portaobjectes de vidre segons les indicacions de la determinació. |
| 11. Després d’obtenir la mostra, pressionar sobre el punt de punció amb una gasa. |
| 12. Deixar el pacient en una posició còmoda i adequada que li permeti fàcil accés al timbre i als objectes personals. |
| 13. Recollir el material utilitzat i rebutjar els residus als contenidors específics. |
| 14. Acomiadar-se del pacient. |
| 15. Treure’s els guants i realitzar la higiene de les mans. |
| 16. Enregistrar el procediment, anotar el resultat i els elements que hi hagin pogut influir (canvis en l’alimentació, activitat…) |
| OBSERVACIONS |
| • Actualment hi ha dispositius per punxar que es poden utilitzar en altres zones. • Cal tenir l’aparell mesurador i les tires reactives en bon estat. |
Recollida de sang venosa
La sang s’acostuma extreure d’una vena perifèrica, les més utilitzades són les del braç i les de la mà (vegeu figura). S’escullen venes que siguin flexibles i rectes, i no s’han de fer servir les venes inflamades o les molt sinuoses. En els nens s’usen més les venes epicranials, en els adults les venes de la mà i de l’avantbraç, i en els ancians les de l’avantbraç, ja que les de la mà solen ser molt sinuoses i, per tant, més difícils de fixar.
Trobareu la versió imprimible d’aquest i altres protocols als annexos de la unitat.
La recollida de sang venosa és la tècnica d’extracció de sang utilitzada amb més freqüència, ja que s’utilitza per a les determinacions convencionals en sang:
- Recompte de glòbuls vermells: nombre, mida i tipus de glòbuls vermells a la sang.
- Recompte de glòbuls blancs: nombre i tipus de glòbuls blancs a la sang.
- Recompte de plaquetes: nombre i mida de les plaquetes.
- Hemoglobina: proteïna rica en ferro en els glòbuls vermells que transporta l’oxigen.
- Hematòcrit: quantitat d’espai que prenen els glòbuls vermells a la sang.
- Recompte de reticulòcits: nombre de glòbuls vermells joves a la sang.
- Mitjana del volum corpuscular mitjà: grandària mitjana dels glòbuls vermells.
- Recompte sanguini complet o hemograma. Inclou la major part o la totalitat d’aquestes proves i és una de les proves de sang més comunes.
Per extreure sang a un pacient se li demana que estiri el braç i el recolzi sobre una superfície amb el palmell de la mà cap amunt. Si és al llit, se li pot col·locar un coixí.
En general, el material per a l’extracció de sang és el següent:
- Sistema de compressió: banda de goma elàstica
- Guants d’un sol ús
- Gasa o cotó
- Esparadrap
- Alcohol o un altre antisèptic
- Sistema de punció. És diferent segons el tipus de mostra a obtenir: catèter, agulla amb o sense xeringa, agulles d’extracció al buit, agulles amb o sense ales.
- Tubs per a la recollida de les mostres
La finalitat del sistema de compressió és provocar una estasi venosa que faci més visible la vena, col·lapsar parcialment el retorn venós i aconseguir així augmentar de calibre la vena. Per aconseguir-ho s’aplica una goma elàstica per sobre del lloc escollit per a la venopunció.
Estasi
Disminució del flux de la sang per compressió.
Sistemes de punció
Els sistemes de punció que s’utilitzen més són el catèter (vegeu figura), les agulles amb o sense ales i el sistema d’extracció al buit. L’elecció d’un d’aquests sistemes depèn de la mostra que s’ha d’obtenir i de les preferències del professional.
El catèter és un dispositiu per crear una via vascular. A més d’utilitzar-se per extreure sang, també s’usa per administrar medicació i fluids endovenosos.
El catèter consta de les parts següents (vegeu figura):
Un catèter és un tub que es pot inserir dins una cavitat del cos, conducte o vas sanguini. Els catèters permeten el drenatge, l’administració de fluids o gasos o l’accés dels instruments quirúrgics.
- Funda protectora
- Catèter. És un tub flexible que acaba en un con de connexió.
- Fiador metàl·lic. Va introduït en el catèter i sobresurt per la seva punta, i permet puncionar la vena.
- Llengüetes i cambra de reflux. Va a l’extrem oposat a la inserció, té unes petites llengüetes de suport per als dits i una cambra que permet observar si reflueix la sang en el moment que es fa la punció.
El catèter endovenós normalment es fixa amb un apòsit adhesiu. (vegeu figura) Aquesta via es pot mantenir en el pacient per si fos necessària per a l’administració de medicaments de fluïdoteràpia i per a l’extracció de sang. La mida del catèter depèn del calibre de la vena que s’ha de puncionar.
El sistema d’extracció tancat té com a característica fonamental establir un circuit tancat des de la vena del pacient fins a l’interior dels tubs. D’aquesta manera, les condicions de seguretat en l’obtenció de la mostra augmenten en evitar tot contacte amb l’exterior i, per tant, qualsevol possibilitat de contaminació.
Aquests sistemes de buit es componen de dos elements:
- Agulla hipodèrmica estèril d’un sol ús
- Portatubs.
L’agulla té la punta afilada en els dos extrems. Amb un extrem es realitza la venopunció i en l’altre, la part distal de l’agulla que no està en contacte amb la vena, hi ha una “vàlvula” que experimenta una retracció en ser pressionada pel tub i l’agulla perfora el tap d’un tub d’obtenció de mostres de sang. Quan es treu, recupera la seva posició inicial. La funció de la vàlvula és evitar la sortida de sang en una extracció múltiple. L’agulla va acoblada a un cilindre de plàstic que proporciona seguretat contra les punxades accidentals (vegeu figura).
Els tubs per contenir la sang poden ser de diversos tipus. El material de què estan fets pot ser plàstic o vidre transparent. Porten acoblat un tap per al tancament hermètic. El color del tap indica si el tub per a sang està buit (sense anticoagulant) o si porta un anticoagulant, i de quin tipus és. Tot i això, a l’etiqueta que porta el tub també s’hi indica el tipus d’anticoagulant (vegeu figura).
Vacutainer és una marca comercial de Becton, Dickinson and company per a un tub d’assaig específicament dissenyat per a la venopunció. El sistema consisteix a extreure sang intravenosa al buit i específicament de la regió cubital del braç.
| PROTOCOL DE RECOLLIDA DE MOSTRA DE SANG VENOSA |
|---|
| És la tècnica d’extracció de sang utilitzada amb més freqüència, ja que s’utilitza per a les determinacions convencionals en sang. |
| OBJECTIU |
| • Conèixer els valors de components de la sang. |
| MATERIAL NECESSARI |
| • Guants d’un sol ús • Gasa o cotó • Esparadrap • Alcohol o un altre antisèptic • Sistema de punció escollit • Tubs per a la recollida de les mostres |
| PROCEDIMENT |
| 1. Rentar-se les mans i posar-se els guants. |
| 2. Verificar que el pacient hagi complert les instruccions prèvies a l’extracció. |
| 3. Explicar al pacient el procediment, preservar la seva intimitat i col·locar-lo en la posició adequada per a la venopunció. |
| 4. Constatar que el material que s’ha d’utilitzar és a l’abast i verificar la concordança entre la petició analítica i els tubs. |
| 5. Assegurar-se que el pacient té la mà tancada. |
| 6. Seleccionar la vena. |
| 7. Desinfectar la zona de punció amb un cotó o gasa humida en alcohol o un altre antisèptic. |
| 8. Elegir el lloc per a la venopunció. |
| 9. Aplicar la banda de goma uns 10 o 15 cm per sobre del lloc de la venopunció per tal de provocar una compressió. Si és necessari, es pot afavorir la dilatació del vas amb diverses maniobres: friccionant l’extremitat per sota del torniquet, obrint i tancant el puny, fent copets amb el dit, aplicant calor amb una compresa calenta o friccionant la zona amb alcohol. |
| 10. Procedir a la punció venosa per part del diplomat en infermeria, per obtenir una mostra en diferents tubs segons les proves que s’hagin de fer. Normalment n’hi ha prou amb l’extracció de 10 ml de sang endovenosa. |
| 11. Tractar la zona de punció després de l’extracció. Col·locar l’apòsit de cel·lulosa mantenint una pressió suau sobre el punt de punció. Recomanar al pacient que mantingui aquesta pressió durant un temps no inferior als 5 minuts i que mantingui el braç en posició elevada un cert temps. |
| 12. Identificar els tubs amb les etiquetes del pacient. Els tubs s’han de disposar en gradetes fins al moment en què arribin al laboratori. |
| 13. Treure’s els guants i rentar-se les mans. |
La prova d’Allen consisteix a pressionar les artèries radial o cubital al canell, per provocar que el palmell de la mà es posi blanc. En condicions normals, quan les artèries es deixen de pressionar, la pell es torna rosada i s’anivella. Si no s’anivella en cinc segons, indica baix flux sanguini, per la qual cosa es necessita seleccionar un altre lloc per a la punció.
Trobareu la versió imprimible d’aquest i altres protocols als annexos de la unitat.
Recollida de sang arterial
A vegades és necessari obtenir sang arterial per a mesurament de gasos respiratoris. La mostra de sang arterial permet determinar el pH i les pressions parcials d’oxigen i diòxid de carboni.
És important informar el pacient sobre el tipus de prova perquè estigui preparat i informat, i explicar-li que la prova pot ser dolorosa. Convé tranquil·litzar-lo i evitar una ansietat innecessària, que pot provocar hiperventilació.
La mostra pot ser recollida per personal mèdic o personal d’infermeria segons els procediments o instruccions de cada centre. La selecció de la xeringa, l’agulla i l’anticoagulant és important. Es recomana la utilització de les xeringues comercials, que contenen heparina liofilitzada i tap de seguretat. L’elecció del lloc de punció es fa tenint en compte els criteris següents: flux sanguini col·lateral, accessibilitat, mida dels vasos, risc de complicacions i existència d’edema.
És aconsellable abans de la punció prefixar l’èmbol de la xeringa amb el volum que es pot autoomplir. La pressió sistòlica normal de les arteries sol ser superior a 100 mmHG/13 kPa. Aquesta alta pressió és el que permet que la xeringa es pugui autoomplir.
Tot just després de l’extracció és necessari verificar si la xeringa conté bombolles d’aire, que s’han d’expulsar cobrint la punta de la xeringa amb una gasa i donant uns copets sostenint-la en posició vertical. Immediatament després d’eliminar les bombolles d’aire, la xeringa ha de ser agitada suaument per afavorir la barreja de la sang amb l’heparina liofilitzada.
Mostres d'orina
L’orina és un líquid aquós, transparent i groguenc, d’olor característica, que excreten els ronyons i s’expulsa a través de l’aparell urinari. L’orina contribueix a mantenir l’homeòstasi.
Homeòstasi
Tendència a mantenir l’equilibri i l’estabilitat interna de l’organisme.
Algunes malalties poden alterar el volum d’orina, les seves característiques i la composició. Per aquest motiu, l’anàlisi d’orina és una de les més habituals.
Una de les tasques de l’auxiliar d’infermeria és la recollida de mostres d’orina i l’observació de l’orina recollida, que pot presentar variacions en el volum de la micció i també en l’aspecte i la composició.
Variacions del volum
La diüresi és la quantitat d’orina eliminada en un període de temps determinat. En un adult el volum normal oscil·la entre 1 i 1,5 l diaris.
Hi ha factors que poden alterar el volum d’orina excretada:
- La ingestió de líquids i aliments amb elevat contingut en aigua n’eleva el volum.
- Les temperatures elevades, l’exercici físic intens i la sudoració disminueixen la diüresi.
- També el consum d’alguns medicaments pot alterar el volum d’orina. Algunes malalties com la diabetis i la diarrea també el modifiquen.
Segons el volum d’orina eliminada es parla de:
- Poliúria: eliminació de més de 2.000 ml d’orina al dia. La poliúria és un dels signes de la diabetis mellitus.
- Oligúria: eliminació de volums diaris d’orina menors de 500 ml. Es dona en la nefrosi.
- Anúria: eliminació de menys de 100 ml d’orina al dia. L’anúria està associada a situacions d’extrema gravetat, com obstruccions de les vies urinàries.
El nombre de vegades que una persona orina també és variable. Es considera dins de la normalitat que una persona adulta realitzi unes quatre o cinc miccions diàries d’un volum d’entre 200 a 300 ml cada una. No se solen produir miccions durant la nit, excepte si s’han ingerit líquids en quantitats excessives.
Les alteracions en el nombre de miccions són:
- Disúria: miccions dificultoses o amb dolor.
- Pol·laciúria: miccions molt freqüents i en petites quantitats.
- Nictúria: miccions nocturnes freqüents.
- Tenesme vesical: desig d’orinar després d’haver miccionat.
- Incontinència urinària: pèrdues urinàries involuntàries.
- Retenció urinària: impossibilitat per orinar. Hi ha circumstàncies no orgàniques que influeixen directament en la micció i produeixen retenció urinària. Un exemple és la falta d’intimitat o no disposar del temps necessari.
- Enuresi: miccions involuntàries durant el son.
Variacions en el color, la transparència i l’olor
L’orina té un color groc-daurat més o menys clar degut a la presència de pigments com l’urocrom. És transparent i només s’enterboleix quan es deixa un temps en repòs i es formen sals que precipiten. Té una olor suau i característica.
-

- Orina de color groc-daurat recollida en un pot
També pot adquirir altres colors si s’han ingerit alguns medicaments o aliments:
- Color ataronjat pel consum de fàrmacs, com la rifampicina, la levodopa o el metronidazol.
- Color vermell pel consum de remolatxa o vitamines del grup B. Encara que el color vermell pot ser signe de patologia, perquè pot indicar la presència de sang (hematúria).
- Color marró-cola per la presència de bilirubina, que indica un problema hepàtic. S’anomena colúria.
- Pot tenyir-se d’un color verdós en infeccions per pseudomones. Les infeccions també enterboleixen l’orina.
-

- Orina tenyida de vermell fosc per hematúria
Els consum d’alguns aliments també modifica l’olor de l’orina. Per exemple, el consum d’espàrrecs o cebes. Hi ha malalties que donen una olor característic a l’orina. És el cas de la presència d’acetona en l’orina, que dona una olor dolça i afruitada. L’acetona pot estar present en situacions de dejú o en pacients diabètics.
Variacions en la composició
Les variacions en la composició es detecten en l’anàlisi al laboratori:
- Glucosúria: presència de glucosa, que ocorre sobretot en la diabetis mellitus.
- Hematúria: presència de sang, que pot ser símptoma d’infecció urinària, litiasi urinària, glomerulonefritis, neoplàsies (càncer de bufeta, urèter, ronyó, pròstata, etc.).
- Bacteriúria: presència de bacteris, ja que normalment és estèril.
- Piúria: presència de pus.
- Proteïnúria: presència de proteïnes, que poden indicar glomerulonefritis, infecció urinària, intoxicacions, diabetis, etc.
- Leucocitúria: presència de glòbuls blancs per sobre dels valors normals.
Segons les dades que es busqui obtenir de l’anàlisi d’orina, s’utilitzen tècniques de recollida diferents:
- Recollida de mostra d’una sola micció per a anàlisi elemental
- Recollida de mostra d’orina per urocultiu
- Recollida d’orina pel control de la diüresi
Recollida de mostra d’una sola micció per a anàlisi elemental
La recollida d’una sola micció per a anàlisi elemental consisteix a recollir una mostra d’orina per determinar-ne les característiques fisicoquímiques, així com fer-ne un estudi microscòpic.
Se sol usar l’orina de la primera micció del matí, ja que és una orina que es troba més concentrada. Si el pacient és autònom, la pot recollir ell mateix seguint les indicacions de l’auxiliar. En cas contrari, la mostra l’ha d’obtenir l’auxiliar.
| PROTOCOL DE RECOLLIDA DE MOSTRA D’ORINA SIMPLE |
|---|
| OBJECTIU |
| • Consisteix en la recollida d’orina d’una sola micció en un recipient estèril. |
| MATERIAL NECESSARI |
| • Guants d’un sol ús • Pot de recollida de boca ampla i amb tap de rosca • Ampolla o orinal pla (per a pacients enllitats) |
| PROCEDIMENT |
| 1. Rentar-se les mans i posar-se els guants. |
| 2. Explicar al pacient que ha de rebutjar la primera part de la micció i que la resta l’ha de recollir en el recipient de recollida estèril. |
| 3. Assegurar que el recipient està perfectament tancat. |
| 4. Identificar la mostra amb les dades del pacient. |
| 5. Treure’s els guants i rentar-se les mans. |
| 6. Enregistrar el procediment. |
| 7. Enviar la mostra al laboratori. |
| OBSERVACIONS |
| • Si el pacient està enllitat, la recollida la fa l’auxiliar col·locant l’orinal pla o l’ampolla per recollir la primera part de la micció i la resta en el recipient preparat per recollir la mostra. |
Recollida de mostra d’orina per urinocultiu
El cultiu d’orina (urinocultiu o urocultiu) permet el diagnòstic d’infeccions urinàries i la determinació del microorganisme responsable. Les mostres d’orina que es recullen per a urocultiu s’han d’obtenir en unes condicions d’asèpsia molt estrictes perquè la contaminació alteraria els resultats de l’anàlisi.
Trobareu la versió imprimible d’aquest i altres protocols als annexos de la unitat.
L’orina d’elecció és la de la primera micció del matí, perquè aquesta orina està més concentrada i això facilita trobar un nombre de colònies bacterianes suficient per al diagnòstic correcte.
Urinocultiu
Sembra del sediment d’una mostra d’orina per tal de diagnosticar el germen causal d’una infecció. L’orina se sembra en un medi de cultiu i s’incuba. Passades 24-48h es comprova si hi ha creixement de microorganismes i s’obtenen els resultats fent el recompte de colònies bacterianes i la identificació del microorganisme responsable.
La mostra d’orina es pot obtenir a través de diversos sistemes:
- Micció mitjana, igual que en la recollida d’una mostra simple d’orina
- Sonda vesical
- Punció suprapúbica
- Orina d’uretrostomia i nefrostomia
Sempre que el pacient pugui recollir l’orina per si mateix se li permet fer-ho, explicant-li, preservant la seva intimitat i la seva autonomia. Si el pacient no pot prendre la mostra o està sondat, la recollida l’efectuarà l’auxiliar d’infermeria.
| PROTOCOL DE RECOLLIDA DE MOSTRA D’ORINA AMB SONDATGE VESICAL |
|---|
| OBJECTIU |
| • Obtenció d’una mostra d’orina suficient a través de la sonda als pacients portadors de sondatge vesical. |
| MATERIAL NECESSARI |
| • Guants • Recipient d’orina estèril • Pinça de Kocher • Agulla estèril • Xeringa de 20 ml estèril • Povidona iodada • Alcohol 70º • Gases • Etiqueta d’identificació |
| PROCEDIMENT |
| 1. Preparació del pacient i del personal: • Explicar al pacient el procediment que se li farà i com pot col·laborar-hi, si està conscient. • Pinçar la sonda vesical per la seva part més distal abans d’arribar a la connexió amb la bossa col·lectora, durant una hora. • Col·locar el pacient en una posició adequada. • Preservar la intimitat durant la realització del procediment. |
| 2. Rentat higiènic de mans i col·locació de guants. |
| 3. Desinfectar el lloc de punció (dispositiu específic per a la presa de mostres) amb povidona iodada i esperar que s’eixugui 1-3 minuts. |
| 4. Punxar la sonda en la zona i aspirar 10-20 ml d’orina, que es traspassaran a un pot estèril. |
| 5. Buidament del contingut de la xeringa al recipient estèril evitant el contacte amb les mans. |
| 6. Despinçament de la bossa i identificació de la mostra. |
| 7. Rentar les restes de povidona iodada. |
| 8. Retirar els guants i rentat higiènic de mans. |
| 9. Portar la mostra al laboratori al més aviat possible o deixar-la a la nevera un màxim de 72 hores. |
| OBSERVACIONS |
| • No recollir mai la mostra d’orina de la bossa. • No desconnectar mai la bossa de la sonda per recollir una mostra. • Comprovar la identificació de les mostres abans de cursar-les al laboratori. • Col·locar-se guants per manipular les mostres. • Anotar la data de recollida de la mostra i les possibles incidències en el full de curs clínic. |
| PROTOCOL DE RECOLLIDA DE MOSTRA D’ORINA SENSE SONDATGE VESICAL |
|---|
| OBJECTIU |
| • Obtenció d’una mostra d’orina (20 ml) per micció. |
| MATERIAL NECESSARI |
| • Guants • Recipient d’orina estèril • Material necessari per a la higiene de genitals • Etiqueta d’identificació • Cunya/ampolla |
| PROCEDIMENT |
| 1. Preparació del personal i del pacient: • Explicar al pacient el procediment que se li farà i com pot col·laborar-hi (si està conscient). • Preservar la intimitat durant la realització del procediment. • Realitzar rentat higiènic de mans i col·locar-se guants. |
| 2. Acompanyar el pacient al bany si és autònom o col·locar la cunya si el pacient està enllitat. |
| 3. Realitzar la higiene de genitals segons protocol: |
| En dones: rentar els genitals externs amb aigua i sabó de davant cap endarrere. Separar els llavis majors i menors, mantenint-los separats en tot moment fins que s’hagi recollit l’orina. |
| En homes: retreure la pell prepucial, rentar els meats amb aigua i sabó. |
| 4. Obrir el recipient, procurant que el voraviu no entri en contacte amb res per evitar la contaminació de la mostra. |
| 5. No utilitzar el primer raig de micció i sense parar recollir en el recipient un mínim de 20 ml. |
| 6. Deixar que finalitzi la micció a la cunya, ampolla o WC. |
| 7. Tancar el recipient. |
| 8. Retirar la cunya, si està enllitat. |
| 9. Retirar els guants i rentat higiènic de mans |
| 10. Etiquetar la mostra i avisar al servei de recollida corresponent per portar-la immediatament al laboratori o a la nevera durant un màxim de 72 hores. |
| OBSERVACIONS |
| • Per evitar la contaminació és necessari realitzar una higiene correcta de genitals i utilitzar els recipients apropiats. • Realitzar la recollida a primera hora del matí, tenint en compte que almenys hagin transcorregut 4 hores des de l’última micció. • Si el pacient és autònom afavorir la seva independència per recollir la mostra, però ser-hi present per ajudar-lo. • Comprovar que els recipients estan identificats abans d’enviar-los al laboratori. • Col·locar-se guants per manipular les mostres. • Anotar la data de recollida de la mostra i les incidències sobre la recollida en el curs clínic. |
-

- Recipient per recollir orina estèril (font: Institut Català de la Salut)
Trobareu la versió imprimible d’aquest i altres protocols als annexos de la unitat.
Trobareu la versió imprimible d’aquest i altres protocols als annexos de la unitat.
Hi ha pacients que per les seves característiques necessiten un procediment una mica diferent per a la recollida d’orina. És el cas dels lactants o dels ancians incontinents.
Recollida de mostres en lactants
En els nens menors de dos anys el procediment de recollida és diferent, ja que es fa amb bosses adhesives (figura). Normalment són els pares els que recullen la mostra i se’ls ha d’explicar com fer-ho.
| PROTOCOL DE RECOLLIDA DE MOSTRA D’ORINA EN LACTANTS |
|---|
| OBJECTIU |
| • Consisteix en la recollida d’orina de lactant. |
| MATERIAL NECESSARI |
| • Guants d’un sol ús • Pot de recollida de boca ampla i amb tap de rosca • Bosses adhesives perineals especials per a lactants • Gases estèrils |
| PROCEDIMENT |
| 1. Rentar-se les mans i posar-se els guants. |
| 2. Explicar la tècnica als pares, demanant-los col·laboració. |
| 3. Retirar el bolquer. Verificar que el nen no hagi miccionat recentment i comprovar que el bolquer està sec. |
| 4. Col·locar la criatura amb les cames obertes en decúbit supí, o posició de granota, per a la qual cosa a vegades és necessària l’ajuda d’una altra persona. |
| 5. Realitzar la neteja genital amb una gasa humitejada amb aigua. Mantenint els llavis separats, efectuar moviments sempre de dalt cap baix i de dins cap enfora. Es continua amb els engonals i la regió anal. Es llença la gasa anterior i amb una gasa nova s’esbandeix, es deixa assecar a l’aire o s’asseca amb una tercera gasa, seguint el mateix ordre. |
| 6. Treure’s els guants, rentar-se les mans i posar-se uns altres guants. |
| 7. Obrir la bossa que conté la bosseta de recollida i treure el paper que recobreix l’adhesiu, començant per la part inferior i procurant no manipular la part interna. Fixar la bossa a la pell, centrant-la en els llavis majors de la nena i sense incloure la zona anal. |
| 8. Identificar la mostra amb les dades de la pacient. |
| 9. Treure’s els guants i rentar-se les mans. |
| 10. Enviar la mostra al laboratori com abans millor. |
| En els nens: |
| 5. Realitzar la neteja genital amb una gasa humitejada amb aigua. Començar pel gland, retirant el prepuci cap enrere tant com sigui possible. Posteriorment, es fa la neteja de la resta del penis, els testicles i els engonals. Per últim, es neteja la regió anal. Es rebutja la gasa anterior i s’asseca amb una altra gasa mantenint el mateix ordre. |
| 6. Treure’s els guants, rentar-se les mans i posar-se uns altres guants. |
| 7. Obrir la bossa que conté la bosseta de recollida, retirar el paper que recobreix l’adhesiu i col·locar el penis a l’interior de la bossa, fixant-la bé a la pell. |
| 8. Quan el nen hagi orinat, es retira la bossa sense tocar la part interna. |
| 9. Identificar la mostra amb les dades del pacient. |
| 10. Treure’s els guants i rentar-se les mans. |
| 11. Enviar la mostra al laboratori com més aviat millor. |
| OBSERVACIONS |
| • Si en 30 minuts la criatura no ha miccionat, es canvia la bossa i es torna a efectuar la higiene genital. També es canvia la bossa en cas que s’embruti o es desenganxi. |
Recollida d’orina per al control de la diüresi
En el cas del control de la diüresi es recull tota l’orina que s’elimina durant 12 o 24 hores segons les indicacions. La diüresi és l’excreció d’orina tant en termes quantitatius com qualitatius. També es defineix com la quantitat d’orina produïda durant un temps. Aquest tipus de recollida es fa quan interessa conèixer si el funcionament renal és correcte i per a l’estudi de la litiasi renal.
Trobareu la versió imprimible d’aquest i altres protocols als annexos de la unitat.
| PROTOCOL DE RECOLLIDA D’ORINA PER AL CONTROL DE LA DIÜRESI |
|---|
| OBJECTIU |
| • Consisteix a recollir durant 12 o 24 hores l’orina eliminada pel pacient, amb la finalitat de mesurar el volum total excretat per via urinària. |
| MATERIAL NECESSARI |
| • Guants d’un sol ús • Recipients de plàstic amb capacitat d’1 a 2 l i tap de rosca |
| PROCEDIMENT |
| 1. Rentar-se les mans i posar-se els guants. |
| 2. Explicar la tècnica al pacient i demanar-li que col·labori. |
| 3. Indicar al pacient que ha de llençar la primera micció del matí (per exemple, la de les 8 del matí). A partir d’aquest moment, recollir tota l’orina emesa, incloent la primera micció del dia següent coincidint amb l’hora que es va llençar la del dia anterior (en l’exemple, les 8h). |
| 4. La recollida es pot realitzar en recipients petits que després s’aboquen al contenidor gran graduat. |
| 5. Rentar-se les mans i posar-se els guants. |
| 6. Identificar la mostra amb les dades del pacient. |
| 7. Treure’s els guants i rentar-se les mans. |
| 8. Enviar la mostra al laboratori com abans millor. |
| OBSERVACIONS |
| • Segons l’estudi que s’hagi de realitzar, a vegades cal mantenir els recipients protegits de la llum o introduir algun conservant al recipient abans de començar la recollida. • Si el pacient llença per error o oblit l’orina d’alguna micció, s’ha de registrar fent una estimació del volum perdut. A vegades és convenient tornar a començar. • De vegades, quan s’està recollint la mostra d’orina en el recipient de 24 hores, és necessari enviar una mostra al laboratori. S’ha de barrejar l’orina del contenidor gran mitjançant una vareta i se n’extreu una petita quantitat, anomenada alíquota, per enviar al laboratori. S’ha de registrar. |
-

- Recipient de plàstic amb tap de rosca
Trobareu la versió imprimible d’aquest i altres protocols als annexos de la unitat.
Mostres de femta
La femta és un bon indicador de l’estat de l’intestí i la salut. Es poden detectar infeccions, problemes metabòlics o hormonals… Habitualment hi ha una correlació directa entre la forma i consistència de la femta i la quantitat de temps que ha passat en el còlon (a causa de molts factors com la hidratació, restrenyiment o manca de la dieta).
En les anàlisis de matèria fecal indispensables per al diagnòstic de moltes malalties gastrointestinals i d’altres tipus, la interpretació dels resultats té en compte, entre altres dades, l’edat del pacient. Les anàlisis més habituals són el coprocultiu, l’anàlisi parasitològica, l’anàlisi de sang oculta i la digestió de principis immediats.
Per conèixer quina seria la femta correcta existeix l’escala de femta de Bristol, que consisteix en una taula visual destinada a classificar la forma de la femta humana en set grups. Va ser desenvolupada per Heaton i Lewis a la Universitat de Bristol i es va publicar per primera vegada l’any 1997.
-

- Escala de femta Bristol
- Tipus 1: són excrements durs i separats, com boletes, i difícil d’evacuar. Són indicadors de restrenyiment i deshidratació. Aquest tipus de femta és comuna en persones amb un estil de vida poc saludable i amb dietes baixes en fibra.
- Tipus 2: també hi ha un procés de restrenyiment, però és menys perillós i dolorós que l’anterior. Aquestes evacuacions semblen com una salsitxa amb volum.
- Tipus 3: són evacuacions considerades normals. Són com una salsitxa, però amb unes esquerdes a l’exterior. Consumint més aigua millora el seu aspecte, fent-la més suau i reduint les esquerdes. Tanmateix, aquest tipus de femta, juntament amb la tipus 4, és la que es troba dins els paràmetres saludables.
- Tipus 4: posseeix la forma anterior de salsitxa, però amb l’extra d’aigua que la fa perfecta per a ser expulsada. És la femta perfecta.
- Tipus 5: hi ha un excés d’aigua, fet que provoca que a poc a poc es perdi la forma i l’estructura i passi a ser amb trossos de consistència més pastosa. Generalment aquest tipus de femta s’acaba expulsant després d’àpats molt copiosos.
- Tipus 6: són evacuacions amorfes i irregulars, pràcticament són una massa formada per trossos petits i esponjosos. Són femtes diarreiques o un principi de diarrea.
- Tipus 7: és la femta més líquida de totes, pràcticament no hi ha matèria sòlida i tot és líquid. Pot ser diarrea greu causada per una infecció bacteriana o viral.
No només la forma i la consistència és important, també el color, el volum i l’olor poden indicar algun tipus de trastorn.
El color habitual de la femta és marró cafè, i admet tons més clars o més foscos. Altres colors són el verd, el groc, el vermell o el negre, que poden ser causats pel consum de certs aliments o medicaments. Per exemple, el negre pot ser causat pels suplements de ferro.
Una femta de gran volum, massa tova i brillant pot indicar la presència de greixos, proteïnes o hidrats de carboni sense digerir.
La coloració negrosa pot alertar de sang digerida procedent d’hemorràgies de tracte digestiu superior, mentre que un color vermell indica la presència de sang procedent de l’intestí gros.
La bilis és qui atorga color a la femta. Una manca de color pot indicar problemes hepàtics. Acòlia és la manca de color en la femta.
El coprocultiu, o examen coproparasitoscòpic, és un cultiu a partir de matèria fecal. És un mètode de diagnòstic microbiològic que permet identificar diferents organismes causants de malalties gastrointestinals. S’utilitza per estudiar casos de diarrea severa, persistent o recurrent (vegeu figura).
La matèria fecal per a coprocultiu ha d’estar lliure de contaminants com orina o paper higiènic.
| PROTOCOL DE RECOLLIDA DE MOSTRES FECALS |
|---|
| OBJECTIU |
| • Obtenir una mostra de femta. |
| MATERIAL NECESSARI |
| • Guants • Recipient (el més idoni és el pot estèril amb cullereta) • Espàtula o depressor • Cunya • Etiqueta d’identificació • Escovilló (si la mostra és escassa o hi ha manca de deposició) • Xeringa (si la femta és líquida) |
| PROCEDIMENT |
| 1. Preparació del pacient i el personal: • Explicar al pacient el procediment i com pot col·laborar-hi (si està conscient). • Col·locar una cunya si el pacient està enllitat. Si el pacient és autònom i pot col·laborar, se li explica que ha de fer la deposició a la cunya, no al WC, per poder recollir la mostra. • Preservar la intimitat del pacient mentre realitza la deposició. |
| 2. Fer un rentat higiènic de mans i posar-se guants. |
| 3. Si la deposició és sòlida, recollir amb una espàtula una mostra de la femta de la cunya. |
| 4. Si la deposició és líquida, recollir amb una xeringa uns 5-10 ml de la part més mucosa i sangonosa. |
| 5. Identificar la mostra. |
| 6. Retirar els guants i fer rentat higiènic de mans. |
| Per a coprocultiu: |
| 1. Recollir la mostra al pot estèril amb cullereta. Si la mostra no és suficient, s’utilitza l’escovilló. Si no hi ha hagut deposició, s’introdueix l’extrem de l’escovilló a l’anus i es guarda la mostra a l’envàs. |
| 2. Identificar la mostra. |
| 3. Retirar els guants i fer rentat higiènic de mans. |
| 4. Enviar la mostra al més aviat possible al laboratori. |
| OBSERVACIONS |
| • Per evitar les mostres mal recollides és necessari utilitzar els recipients adequats. • Cal obtenir una quantitat suficient de la mostra. • Si el pacient és autònom, s’ha d’afavorir la seva independència i recollir la mostra una vegada realitzada la deposició. • Cal col·locar-se guants per manipular les mostres. |
-

- Mitjans de transport per a mostres de femta
Trobareu la versió imprimible d’aquest i altres protocols als annexos de la unitat.
Mostres d'esput
L’esput és la matèria expectorada de les vies respiratòries, com ara mocs o flegma, barrejada amb saliva que pot ser escopida per la boca.
El moc es un líquid viscós segregat per les cèl·lules epitelials que recobreixen totes les parets de l’aparell respiratori des del nas, els sins paranasals, la boca, la faringe, la tràquea i l’interior del pulmó (bronquis i bronquíols). El moc és una barrera defensiva fonamental i la necessària lubricació perquè actuïn els cilis i realitzin la seva funció d’arrossegament.
Observació i valoració de l’esput
El normal és que el moc sigui transparent o blanquinós. Per exemple, que recordi a la clara de l’ou. També és normal que es produeixin dipòsits de moc sec de color fosc a les fosses nasals.
Quan l’expectoració és clara, transparent i fluida no passa res. Quan és densa, groga, verdosa, purulenta o té mala olor, pot indicar infecció. Hi pot haver problemes quan la quantitat de moc és excessiva o és molt espessa. En aquests casos l’organisme l’expulsa mitjançant la tos.
Un moc groguenc o verdós indica que hi ha una infecció i que les defenses de l’organisme estan actuant per evitar que progressi. És habitual que al principi el moc sigui clar i més abundant, i que amb els dies es vagi transformant en més fosc, entre groc i verdós.
A vegades el moc o les flegmes poden dur sang i tenir un color vermellós si es tracta d’una tos crònica, causada possiblement per una malaltia greu com la tuberculosi.
Un moc negre no és freqüent, però pot ocórrer després d’inhalar fum d’un incendi, de respirar en llocs amb elevada contaminació ambiental o en treballadors de mineria del carbó.
Les mostres microbiològiques d’esput són utilitzades habitualment per buscar organismes que causen infeccions dels pulmons i bronquis. Per exemple, bacteris com Mycobacterium tuberculosis, Streptococcus pneumoniae i Haemophilus influenzae i altres microorganismes patògens.
Recollida de mostra d’esput
La recollida d’esput es fa mitjançant una prova no invasiva i fàcil de realitzar. No fa mal ni hi ha altres molèsties severes durant la tècnica, potser només alguna petita molèstia per haver de tossir contínuament per expectorar el moc.
La preparació del pacient només requereix beure aigua, ja que això facilita l’expectoració de mucositat per realitzar la prova correctament.
Per dur a terme la prova els professionals sanitaris demanen al pacient que tussi profundament i intenti expectorar mucositat en un pot estèril, que posteriorment s’envia a laboratori. Es poden demanar tres respiracions profundes per ajudar a expectorar el moc.
| PROTOCOL DE RECOLLIDA D’UNA MOSTRA D’ESPUT |
|---|
| OBJECTIU |
| • Obtenció d’una mostra d’esput |
| MATERIAL NECESSARI |
| Pacient col·laborador: • Guants • Pot estèril de boca ampla • Etiquetes identificadores • Mocadors de paper |
| Pacient no col·laborador: • Guants • Pot estèril • Aspirador • Sonda d’aspiració • Sèrum fisiològic • Gases • Escovilló • Etiquetes identificadores |
| PROCEDIMENT |
| 1. Explicar al pacient el procediment que se li farà i demanar-li la col·laboració. |
| 2. Rentar-se les mans i posar-se els guants. |
| Pacient col·laborador: |
| 3. A primera hora del matí cal que el pacient es renti la boca amb solució salina abans d’expectorar i proporcionar-li un pot estèril, mocadors de paper i estimular-lo perquè tussi: entrenar-lo perquè faci respiracions profundes i provoqui així tos productiva i no sols saliva. |
| 4. Si és necessari, fer-li el repic per ajudar-lo. |
| 5. Indicar al pacient que un cop obtinguda la mostra avisi immediatament. Cal que la mostra es reculli a primera hora del matí i en dejú, i sigui tan abundant com sigui possible. |
| 6. Si porta traqueostomia, recollir la mostra amb escovilló segons el protocol de recollida de frotis. |
| Pacient no col·laborador: |
| 3. Connectar l’equip d’aspiració. |
| 4. Procedir a l’aspirat de secrecions. |
| 5. Quan s’hagi aspirat una part de les secrecions, parar la succió abans de retirar la sonda per tal que en quedi una part a la sonda d’aspiració. |
| 6. Dipositar la mostra obtinguda en el pot estèril. |
| En ambdós casos: |
| 7. Tapar correctament el pot de la mostra. |
| 8. Etiquetar el pot de mostra. |
| 9. Enviar la mostra al més aviat possible al laboratori. |
| 10. En cas d’haver utilitzat aspirador, netejar-lo i emmagatzemar-lo. |
| 11. Retirar-se els guants. |
| 11. Fer el rentat higiènic de mans. |
| OBSERVACIONS |
| • Assegurar-se que la mostra obtinguda no és merament saliva. • Fer la higiene de la boca. • Guardar la mostra a la nevera. • Col·locar-se guants per manipular les mostres. • Comprovar que les mostres estiguin ben identificades abans d’enviar-les al laboratori. • En cas de recollida amb escovilló, assegurar-se que el recipient estigui ben tancat. • En fer el registre cal anotar en la història clínica el dia de la recollida i l’aspecte de la mostra. |
Mostres de vòmits
El vòmit o emesi és la sortida per la boca cap a l’exterior del contingut de l’estómac de forma sobtada. Normalment abans del vòmit el pacient presenta sensació de malestar, sudoració i nàusees. Durant el vòmit, els músculs de la paret abdominal i el diafragma es contrauen per propulsar el contingut gàstric a l’exterior.
Trobareu la versió imprimible d’aquest i altres protocols als annexos de la unitat.
El vòmit s’analitza per detectar elements anòmals, com sang, microorganismes, tòxics, etc.
| PROTOCOL D’ATENCIÓ AL PACIENT DURANT EL VÒMIT |
|---|
| OBJECTIU |
| • Donar suport al pacient. • Controlar que el pacient no aspiri el seu propi vòmit. |
| MATERIAL NECESSARI |
| • Guants d’un sol ús • Gases • Ronyonera o batea |
| PROCEDIMENT |
| 1. Rentar-se les mans i posar-se els guants. |
| 2. Si el pacient està enllitat i conscient, col·locar-lo si és possible semiincorporat. Si està inconscient, col·locar-lo en decúbit lateral amb el cap de costat. |
| 3. Apropar la ronyonera al pit i mantenir-la en aquesta posició fins que el vòmit finalitzi. |
| 4. Tranquil·litzar el pacient i demanar-li que inspiri lentament i profundament per la boca. |
| 5. Netejar-li la suor i les restes de vòmit. |
| 6. Quan s’ha aturat el vòmit, si el pacient està conscient donar-li aigua perquè glopegi. |
| 7. Retirar la ronyonera amb el vòmit. Observar el vòmit i netejar la ronyonera. |
| 8. Netejar el que hagi embrutat, canviar la roba si cal i deixar el pacient acomodat. |
| 9. Airejar l’habitació. |
| 10. Explicar el fet a l’infermer i enregistrar-ho en la història clínica. |
La quantitat, la freqüència i l’aspecte del vòmit poden donar informació sobre la malaltia. En el vòmit s’ha d’observar:
Trobareu la versió imprimible d’aquest i altres protocols als annexos de la unitat.
- Quantitat vomitada.
- Forma d’inici: sense avís previ i amb molta força, vòmit en escopeta o amb la simptomatologia prèvia de malestar, nauses, etc.
- Freqüència, si es repeteix el vòmit.
- Coincidència o no amb els àpats. En cas afirmatiu, si és abans, durant o després de l’àpat.
- Aspecte i olor del vòmit:
- Vòmit amb contingut d’aliments: depèn de l’aliment ingerit i la fase de digestió en què es trobi.
- Vòmit aquós: és molt líquid i transparent i amb olor àcida, quan el contingut són sucs gàstrics.
- Vòmit hemàtic: conté sang. És vermell si és sang recent o negre si ja està digerida.
- Vòmit biliós: degut a la bilis, amb un aspecte verdós i una olor amarga.
| PROTOCOL DE RECOLLIDA D’UNA MOSTRA DE VÒMIT |
|---|
| OBJECTIU |
| • Recollir una mostra de vòmit en un recipient. |
| MATERIAL NECESSARI |
| • Guants d’un sol ús • Recipients estèrils per a presa de mostres • Espàtula |
| PROCEDIMENT |
| 1. Rentar-se les mans i posar-se el guants. |
| 2. Prendre una mostra del vòmit amb una espàtula i guardar-la en un recipient estèril. Aquest recipient no porta additius ni conservants. |
| 3. Identificar la mostra amb les dades del pacient. |
| 4. Treure’s els guants i rentar-se les mans. |
| 5. Enviar la mostra al laboratori com abans millor. |
| OBSERVACIONS |
| • Si la mostra no s’envia immediatament al laboratori, s’ha de conservar a una temperatura de 2°C a 5°C. |
Mostres d'exsudats
Trobareu la versió imprimible d’aquest i altres protocols als annexos de la unitat.
L’exsudat és un líquid extravascular amb una elevada concentració de proteïnes que s’acumula als teixits del cos sotmesos a un procés d’inflamació. Es poden obtenir exsudats nasals, faringis, conjuntivals, òtics, uretrals, vaginals, de fístules, d’úlceres i de ferides, ja que l’exsudació forma part del progrés curatiu de les ferides.
| PROTOCOL DE RECOLLIDA DE FROTIS |
|---|
| OBJECTIU |
| • Realitzar frotis per a cultiu per sospita d’infecció • Obtenir les mostres correctament per a la prova sol·licitada. |
| MATERIAL NECESSARI |
| • Guants • Escovilló estèril amb mitjà de transport de Stuart • Etiquetes identificadores • En el frotis de ferides: gases estèrils, material de cures prescrit |
| PROCEDIMENT |
| 1. Explicar al pacient el procediment i demanar-li la col·laboració, si pot. |
| 2. Rentar-se les mans i col·locar-se la mascareta i els guants. |
| 3. Destapar la ferida. |
| 4. Rentar la zona al voltant de la ferida amb solució neutra i aclarir-la amb solució salina abundant si la ferida és molt bruta. |
| 5. Netejar l’excés d’exsudat amb solució salina. |
| 6. Passar l’escovilló fent un moviment rotatori per la part interna de la ferida que se sospita que pot estar infectada. |
| 7. Dipositar l’escovilló en un recipient. |
| 8. Etiquetar el tub. |
| 9. Curar la ferida i tapar. |
| 10. Retirar-se els guants. |
| 11. Fer el rentat higiènic de mans. |
| 12. Enviar el frotis al més aviat possible al laboratori. |
| OBSERVACIONS |
| • Col·locar-se guants per manipular les mostres. • Comprovar que el recipient estigui ben identificat abans d’enviar-lo al laboratori. • Assegurar-se que l’escovilló estigui ben tancat. • Registre: anotar en història clínica el dia de recollida de la mostra. |
En la recollida d’altres exsudats:
Trobareu la versió imprimible d’aquest i altres protocols als annexos de la unitat.
- De la conjuntiva de l’ull, cal tenir en compte prendre la mostra després d’unes hores d’haver aplicat col·liris i pomades o d’haver-se rentat.
- De la faringe, s’ha d’evitar tocar amb l’escovilló altres parts de la boca.
- De la uretra, la presa de mostra s’ha de realitzar abans de la primera micció del matí. En introduir l’escovilló es fan moviments de rotació dins del conducte per prendre la mostra.
- De la vagina, per a la presa de mostra cal rotar suaument l’escovilló durant 15-30 segons per assegurar una quantitat de mostra adequada i retirar-lo amb cura.
Mostres de líquid cefaloraquidi
El líquid cefaloraquidi (LCR) és un líquid transparent i poc dens que ocupa l’espai entre el sistema nerviós central, l’encèfal i la medul·la espinal i l’estructura òssia, la cavitat cranial i la columna vertebral. Conté aigua, ions de sodi, potassi i clor, algunes proteïnes, glucosa i algunes cèl·lules. La seva funció és protegir, sostenir i nodrir el sistema nerviós central, eliminar substàncies i fer de via de comunicació hormonal.
Els canvis en la quantitat de LCR o en la seva composició poden orientar sobre determinades malalties. Així, pot experimentar canvis pel que fa a la pressió, que pot augmentar per traumes i infeccions que augmentin la pressió intracranial o pot disminuir per tumors o altres causes. També es poden produir alteracions en la seva composició i en l’aspecte.
L’observació d’un LCR tèrbol pot indicar infecció i un color vermellós groguenc o marronós, la presència de sang.
L’anàlisi, pel que fa a glucosa, ions i diferents tipus d’elements cel·lulars com les hematies i els limfòcits, es fa servir per al diagnòstic d’algunes malalties inflamatòries i infeccioses de l’SNC.
Hi ha diversos punts del cos del pacient en què es pot obtenir la mostra d’LCR:
- Punció lumbar: es fa entre la tercera i la quarta vèrtebra lumbar (vegeu figura).
- Punció cisternal: es fa entre la primera vèrtebra cervical, anomenada atlas, i la segona, axis.
- Punció ventricular: es fa dins dels ventricles cerebrals.
L’obtenció d’LCR és una operació delicada que ha de fer un metge i requereix una tècnica molt precisa per evitar danys a l’encèfal o a la medul·la espinal. La forma d’obtenció més habitual, ja que és la més senzilla i segura, és per punció lumbar.
| PROTOCOL DE RECOLLIDA DE MOSTRA D’LCR |
|---|
| OBJECTIU |
| • Obtenció d’una mostra de líquid cefaloraquidi (LCR). |
| MATERIAL NECESSARI |
| • Guants d’un sol ús • Turundes • Agulles espinals • Antisèptic • Anestèsic local • Manòmetre • Tubs de vidre estèril amb tap de rosca per a la recollida de les mostres |
| PROCEDIMENT |
| 1. Rentar-se les mans i posar-se els guants. |
| 2. Explicar al pacient el procediment. |
| 3. Preservar la seva intimitat i col·locar-lo en la posició adequada: en decúbit lateral, a la vorera del llit, en posició fetal. |
| 4. Avisar el pacient que ha de romandre totalment immòbil durant la tècnica, per evitar que l’agulla espinal es mogui i pugui danyar la medul·la espinal. |
| 5. Netejar i desinfectar la zona lumbar. |
| 6. Preparar el camp estèril. |
| 7. Realitzar punció amb un trocar especial amb fiador. |
| 8. Recollir els primers 3-5 cc per a estudi. El volum d’LCR a extraure depèn de les determinacions que s’hagin de fer, en general entre de 2 i 4 ml és suficient. Per a estudis microbiològics s’extreuen fins a 8 ml. |
| 9. Un cop obtingut l’LCR, aplicar el manòmetre a l’agulla per registrar la pressió. |
| 10. Retirar el trocar, cobrir l’orifici de la pell amb una pel·lícula líquida estèril (tipus Novecuttan). |
| 11. Col·locar un apòsit estèril. |
| 12. Indicar al pacient que s’estigui estirat entre 20 minuts i una hora després de l’examen. |
| 13. Identificar els tubs amb les etiquetes del pacient. |
| 14. Treure’s els guants i rentar-se les mans. |
| OBSERVACIONS |
| • Si no s’envia immediatament al laboratori, la mostra s’ha de conservar a una temperatura de 2°C a 5°C. |
Altres tipus de mostres
Els facultatius poden determinar l’obtenció d’altres tipus de mostres per arribar al diagnòstic de la malaltia del pacient.
Trobareu la versió imprimible d’aquest i altres protocols als annexos de la unitat.
- Presa de mostres de teixits i òrgans per a la realització de biòpsies. L’obtenció d’aquestes mostres es fa amb bisturís o trocars o per endoscòpia (vegeu el protocol de recollida de mostres d’una úlcera).
- Presa de mostres de semen en els estudis de fertilitat. S’estudia el volum de semen, el nombre d’espermatozous, la forma i la mobilitat. La mostra l’obté el pacient per estimulació i es recull en un recipient de boca ampla i tap de rosca.
| PROTOCOL DE RECOLLIDA DE MOSTRES D’UNA ÚLCERA PER PRESSIÓ MITJANÇANT ASPIRACIÓ PERCUTÀNIA |
|---|
| OBJECTIU |
| • Obtenir una mostra d’una úlcera per pressió (UPP). |
| MATERIAL NECESSARI |
| • Guants • Gases estèrils • Povidona iodada al 10% • Xeringa estèril • Agulla IM (0,8 mm x 40 mm) • Sèrum fisiològic • Material de cures prescrit • Mitjà de transport • Etiquetes identificadores |
| PROCEDIMENT |
| 1. Preparació del pacient: • Explicar al pacient el procediment i com pot col·laborar-hi si està conscient. • Col·locar-lo en la posició més adequada per a la presa de la mostra. |
| 2. Preparació del personal: • Fer el rentat higiènic de mans. • Col·locar-se els guants. |
| 3. Destapar l’UPP. |
| 4. Desinfectar la pell periulceral amb povidona iodada al 10%. |
| 5. Netejar de forma concèntrica aquesta zona. |
| 6. Deixar eixugar, com a mínim durant un minut, perquè la povidona iodada exerceixi la seva acció antisèptica. |
| 7. Fer la punció a través de la pell periulceral íntegra, seleccionant el costat de la lesió amb major presència de teixit de granulació o amb absència d’esfàcels. |
| 8. Fer una punció-aspiració amb la xeringa i l’agulla, mantenint una inclinació aproximada de 45° i aproximant-se al nivell de la paret de la lesió. En processos no supuratius cal preparar la xeringa amb mig ml de sèrum fisiològic per injectar i aspirar. |
| 9. Dipositar la mostra obtinguda en el mitjà de transport. |
| 10. Etiquetar la mostra. |
| 11. Curar l’UPP. |
| 12. Retirar-se els guants. |
| 13. Fer el rentat higiènic de mans. |
| 14. Enviar la mostra al més aviat possible al laboratori. |
| OBSERVACIONS |
| • Col·locar-se guants per manipular les mostres. • Comprovar que els recipients per enviar les mostres estiguin ben identificats abans d’enviar-los al laboratori. • Registre: anotar en història clínica el dia de la recollida de la mostra i el mètode utilitzat. |
| PROTOCOL DE RECOLLIDA DE MOSTRES D’UNA ÚLCERA PER PRESSIÓ MITJANÇANT BIÒPSIA TISSULAR |
|---|
| OBJECTIU |
| • Obtenir una mostra d’una úlcera per pressió (UPP). |
| MATERIAL NECESSARI |
| • Guants • Gases estèrils • Povidona iodada al 10% • Xeringa estèril • Agulla IM ( 0,8 mm x 40 mm ) • Bisturí • Pinces • Material de cures prescrit • Mitjà de transport • Etiquetes identificadores |
| PROCEDIMENT |
| 1. Preparació del pacient: • Explicar al pacient el procediment i com pot col·laborar-hi si està conscient. • Col·locar-lo en la posició més adequada per a la presa de la mostra. |
| 2. Preparació del personal: • Fer el rentat higiènic de mans. • Col·locar-se els guants. |
| 3. Destapar l’UPP. |
| 4. Pintar amb povidona iodada al 10% la zona seleccionada. |
| 5. Amb ajut d’unes pinces i un bisturí, desbridar quirúrgicament una mostra de teixit de la zona que mostra signes d’infecció. Les mostres líquides s’obtenen per aspiració amb xeringa i agulla. |
| 6. Dipositar la mostra obtinguda en el mitjà de transport. |
| 7. Etiquetar la mostra. |
| 8. Curar l’UPP. |
| 9. Retirar-se els guants. |
| 10. Fer el rentat higiènic de mans. |
| 11. Enviar la mostra al més aviat possible al laboratori. |
| OBSERVACIONS |
| • Col·locar-se guants per manipular les mostres. • Comprovar que els recipients per enviar les mostres estiguin ben identificats abans d’enviar-los al laboratori. • Registre: anotar en història clínica el dia de la recollida de la mostra i el mètode utilitzat. |
Manipulació, conservació i transport de les mostres
Manipular mostres biològiques comporta riscos i, per tant, s’han de prendre totes les mesures per tal d’evitar-los. Sistematitzar cada un dels processos pels quals passa la mostra des de l’obtenció fins a la conservació, transport i eliminació dels residus que genera és la millor manera de reduir els riscos.
Trobareu la versió imprimible d’aquest i altres protocols als annexos de la unitat.
Trobareu la versió imprimible d’aquest i altres protocols als annexos de la unitat.
Mesures de prevenció durant la recollida de les mostres. Les punxades i els talls provocats per agulles i objectes afilats són el principal risc del personal en la recollida de mostres. Les normes bàsiques que cal seguir són les següents:
- Utilitzar una bona tècnica i un bon material per evitar la contaminació de les mans.
- Rentar-se les mans amb aigua i sabó immediatament després de qualsevol accident de contaminació amb agents biològics i al finalitzar el procediment, encara que s’hagin utilitzat guants.
- Evitar que a les mans hi hagi talls, abrasions o altres lesions cutànies que permetin una millor penetració d’agents biològics. És obligatori l’ús de guants.
- No reencaputxar les agulles ni desacoblar-les de la xeringa.
- Rebutjar les agulles, bisturís, etc. en recipients de plàstic rígid imperforable (contenidors grocs).
- Tancar bé els recipients de mostres. Una vegada tancats netejar-los amb alcohol al 70% o un altre desinfectant.
Les mostres recollides en diferents punts de l’hospital han de ser transportades als laboratoris en condicions òptimes per garantir el manteniment de les seves propietats biològiques. S’ha de controlar:
- Etiquetatge i identificació de les mostres
- Envasat
- Condicions de transport
- Temps de transport
Per garantir la seguretat i estabilitat de les mostres durant el transport, es recomana seguir les directrius del Departament de Salut basades en la normativa internacional ADR i que es recullen en el document de la direcció de recursos sanitaris del Departament de Salut titulat “Requisit del transport de mostres de diagnòstic per garantir l’estabilitat de les seves propietats biològiques”. Aquest document exposa una sèrie de requisits referents a la preparació i col·locació dels diferents tipus de tubs/contenidors dins les neveres i les condicions idònies d’embalatge, etiquetatge i senyalització.
L’embalatge consta de tres components:
- Recipient primari (tub/contenidor per cada tipus de mostra).
- Recipient secundari (bossa de plàstic transparent tancada): per al transport de mostres líquides, aquest embalatge ha de ser impermeable per si hi hagués una fuga en un dels recipients primaris.
- Recipient exterior o terciari (nevera o valisa). En la seva superfície exterior hi ha d’haver la senyalització que es tracta de mostres per a diagnòstic (vegeu figura).
Els recipients primaris s’embalen dins dels secundaris de manera que si en les condicions normals de transport es produeix algun trencament, s’eviten fugues del contenidor primari dins l’embalatge terciari.
La nevera ha de reunir tota una sèrie de condicions:
- Ha d’estar neta.
- Ha d’estar refrigerada amb els blocs de gel sintètic.
- Si cal, pot posar-s’hi alguna cosa (tovallola, talla, etc.) que ajudi a mantenir les mostres travades i que no es puguin moure.
Les condicions de transport han de ser les següents:
- Les mostres s’han de mantenir en posició vertical per evitar els vessaments. També s’ha d’evitar agitar-les durant el transport.
- El temps de transport ha de ser el mínim. Per exemple, les mostres de sang no es poden conservar més de 30 minuts.
- La temperatura ha de ser adequada a les característiques de la mostra. Algunes mostres s’han de mantenir congelades, d’altres refrigerades. Per exemple, les mostres de sang s’han de transportar immediatament al laboratori, perquè el metabolisme de la sang no s’atura; i també per evitar la difusió dels gasos a través del plàstic de la xeringa i per evitar l’hemòlisi. En cas que s’hagi de conservar la mostra més de deu minuts, es recomana refredar-la entre 0 i 4 °C per alentir el metabolisme cel·lular.
- La humitat, la pressió atmosfèrica i l’exposició a la llum també poden alterar la mostra i s’han de tenir en compte.
Tots els residus biològics que generin les mostres han de ser eliminats tal com queda regulat en el Decret 27/1999, de 9 de febrer, sobre residus sanitaris.